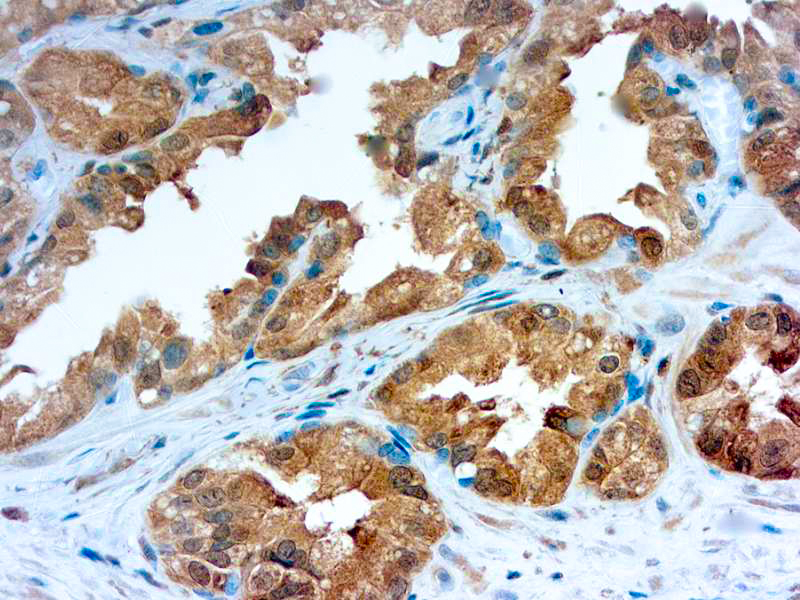

Galectins are a family of soluble β-galactoside-binding animal lectins that modulate cell-to-cell adhesion and cell-to-extracellular matrix (ECM) interactions and play a role in tumor progression, pre-mRNA splicing and apoptosis. The galectin-3 protein, also known as Mac-2, hMac-2, GALBP, CBP35 or LGALS3, contains a single carbohydrate binding domain, which binds galactose-containing glycoconjugates. Galectin-3 is expressed in colonic and intestinal epithelium, inflammatory macrophages, papillary and follicular carcinomas, neoplastic astrocytes and some B and T lymphocytes. Upregulated expression of galectin-3 is involved in cancer progression and metastasis. Galectin-3 mediates the endocytosis of β1 Integrins in a lactose-dependent manner and is associated with thyroid malignancy and Crohn’s disease. It may also be used as a marker for diagnosing casesinvolving Hurthle cell adenomas and carcinomas.
Galectin-3
SKU: Mob541-
Categories: Primary Antibodies, IVD - For U.S. Market, IVD - Outside U.S. Market
Tags: Highlighter Product, HL72K-Core Kit, Concentrated, G
Description
Additional information
| Clone | H-5 |
|---|---|
| Isotype | IgG1 |
| Immunogen | Raised against a synthetic sequence of amino acids 2-31 of human origin |
| Species | Mouse |
| Cellular Localization | Cytoplasmic, Nuclear |
| Positive Control Tissue | Colon carcinoma, papillary thyroid carcinoma |
| Pretreatment | Citrate Buffer pH 6.0 |
| Incubation & Temperature | 30 min @ RT |
| Intended Use | IVD |
| Detection System | PolyVue Plus – Two Step Detection System or Montage PolyVue Plus Auto Detection System for Montage 360 System |
| Description/Type | Mouse Monoclonal Antibody |
| Format | Purified immunoglobulin |
DATASHEETS & SDS
DATASHEETS & SDS
| Download Datasheet |
| Download SDS Sheet – OSHA |
REFERENCES
REFERENCES
- Castronovo et al. J Pathol 179: 43, 1996.
- Fernandez et al. J Pathol 181: 80, 1997.
- Gasbarri et al. J Clin Oncol 17: 3494, 1999.
- Kasper et al. J Pathol 179: 309, 1996.
Reviews (0)
Only logged in customers who have purchased this product may leave a review.

Reviews
There are no reviews yet.